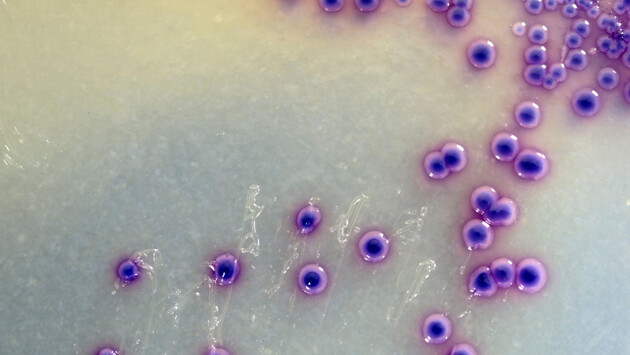
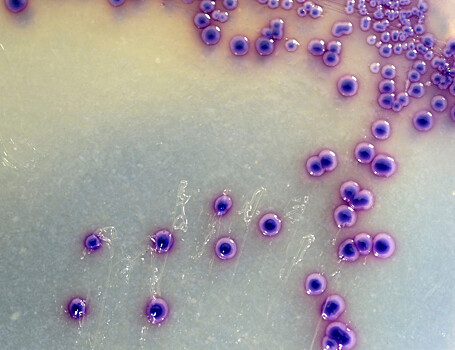
Небольшая спираль мембранного белка оказалась важна для запуска иммунного ответа

Небольшая спираль мембранного белка оказалась важна для запуска иммунного ответа
Когда иммунная клетка встречает патоген, она «знакомится» с ним с помощью специальных белков — толл-подобных рецепторов. У этих рецепторов есть внешний фрагмент, который связывается с врагом, и внутренний, запускающий защитные реакции. Центральная часть белка погружена в мембрану клетки, и теперь биологи из России и Китая выяснили, что там есть небольшая спираль, от структуры которой зависит, среагирует ли толл-подобный рецептор на опасность. Результаты работы, поддержанной Российским научным фондом и опубликованной в журнале Nature Communication, помогут в исследованиях механизмов врожденного иммунитета, а также создании лекарств от аутоиммунных и онкологических болезней, связанных с мутациями в толл-подобных рецепторах.Наш организм постоянно сталкивается с потенциально опасными объектами — бактериями, вирусами, грибками и даже собственными разрушенными клетками. В ходе эволюции он научился вовремя обнаруживать их и запускать защитные реакции. Первую линию обороны составляет врожденный иммунитет. Он реагирует не на определенные молекулы конкретного патогена (за это отвечает адаптивный иммунитет, возникающий, например, после болезни или вакцинации), а на некие общие для целого класса опасностей молекулы. Одни из важнейших участников такого процесса — толл-подобные рецепторы (Toll-like receptor, TLR).Эти достаточно древние белки располагаются в мембране иммунных клеток. Каждый из них специализируется на каком-то патогене, например бактериях или вирусах. После взаимодействия с мишенью от «головы» толл-подобного рецептора снаружи мембраны идет сигнал через погруженную в мембрану «шею» к «ногам», которые уже подают сигнал специальным внутриклеточным белкам, а те запускают каскад реакций. В результате этого клетка начинает вырабатывать защитные и сигнальные молекулы. Так возникает воспалительная реакция — своего рода «оборона», во время которой одни защитники обезвреживают опасные объекты и пытаются минимизировать ущерб, а другие подготавливают условия для восстановления тех тканей, которые могли повредиться.Подробности работы и даже строения толл-подобных рецепторов до сих пор до конца не раскрыты, хотя есть достаточно много данных о структуре их лиганд-связывающих «голов» — эта информация полезна при разработке лекарств и диагностических систем. Вместе с тем ученые практически не уделяли внимание фрагментам, спрятанным в мембране или расположенным у самой ее поверхности. Однако именно они служат передатчиком сигнала вовнутрь, и в случае каких-то поломок в них иммунная клетка просто не отреагирует на опасность, а организм будет уязвим.В своей новой статье сотрудники Института биоорганической химии имени академиков М. М. Шемякина и Ю. А. Овчинникова РАН (Москва) вместе с коллегами из Китая выяснили структуру и возможные функции «шеи» представителей четырех подсемейств TLR — TLR2, TLR3, TLR5 и TLR9, которые связывают бактериальные лиганды (кроме TLR3, его специализация — РНК вирусов).Ученые получили трехмерные структуры мембранных «шей» всех четырех рецепторов. Так им удалось обнаружить ранее неизвестный «позвонок» с внутренней, цитоплазматической стороны. Он представляет собой небольшую ɑ-спираль из цепочки аминокислот, погруженную в мембрану. Далее авторы проанализировали ее последовательность и поняли, что она очень консервативна.«Консервативность говорит о том, что какой-то участок белка в определенный момент оказался "совершенным" и важным в своих функциях настолько, что в дальнейшем практически не изменялся. Найденная ɑ-спираль оказалась сопоставима по консервативности с остатками внутриклеточного домена, который необходим для запуска сигнального каскада. Примечательно, что ее окружение в рецепторе оказалось не столь постоянным», — рассказывает первый автор статьи и исполнитель проекта, поддержанного РНФ, Федор Корнилов, младший научный сотрудник лаборатории биомолекулярной ЯМР-спектроскопии ИБХ РАН.Чтобы понять, чем же найденная спираль столь значима, ученые искусственно внесли в нее мутации, а затем наблюдали, что будет с измененными клетками. Однозначного ответа такие эксперименты не дали. В последовательности аминокислотных остатков TLR2 оказались «закодированы» важные взаимодействия, необходимые для работы комплекса, тогда как мутации в примембранном регионе TLR1 не оказывают влияние на его работу.«Роль того или иного примембранного региона, по-видимому, зависит от конкретного контекста или запускаемого сигнального каскада — в дальнейшем мы планируем подробнее изучить этот вопрос. Но уже сейчас наше исследование закрыло большое белое пятно в структурной биологии толл-подобных рецепторов: считая ранее изученный нами TLR4, теперь для всех пяти подсемейств человеческих рецепторов известно строение мембранных доменов. На основании полученных данных можно будет заниматься компьютерным дизайном новых лекарств от онкологических и аутоиммунных заболеваний, нацеленных на толл-подобные рецепторы», — подводит итог руководитель проекта, поддержанного РНФ, Константин Минеев, доктор химических наук, ведущий научный сотрудник ИБХ РАН.